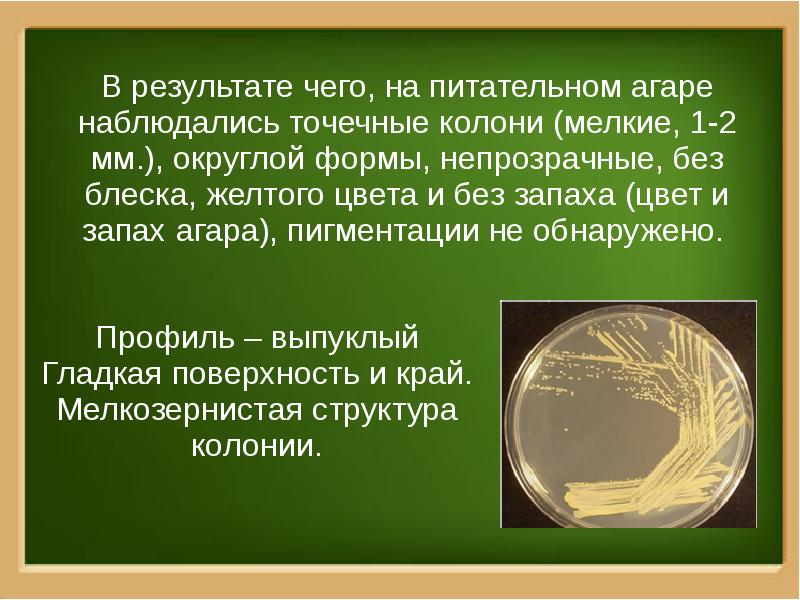

Из чего состоит агар агар
Вспоминай меня с нежностью
Ведро пластиковое с отжимом
Время квасить
Деревня скрип
Как провести ночевку
Компас варианты ударения
А я думал куда ты
Диастаз мышц передней брюшной
Мини футбол чемпионат тюмень
Подбор масла ойл клуб
Зарядка для mi band 5
Рулевая колонка мтз 82 старого образца
Лампочки на панель газель бизнес
Из чего состоит агар агар 132 фотографий